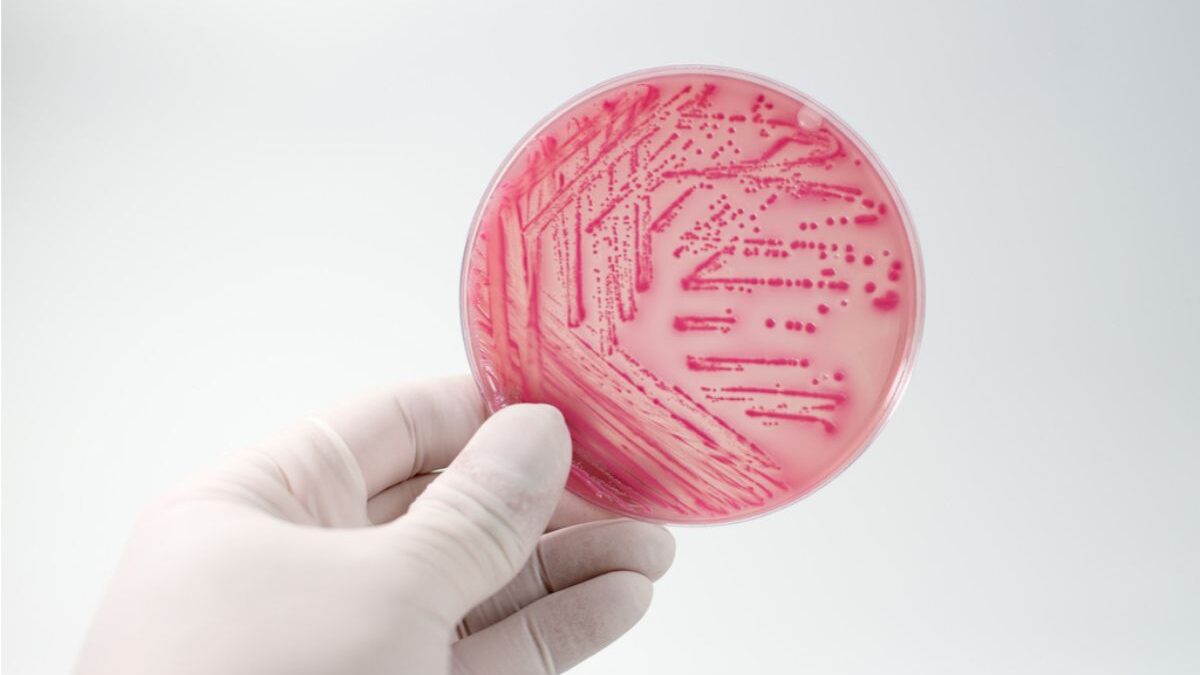

La Escuela Gobernador Díaz celebra una nueva edición de su tradicional Fiesta de la Tradición
octubre 30, 2025Un niño de dos años permanece internado en el Hospital de Niños de Córdoba. Las autoridades locales activaron los protocolos preventivos y piden extremar los cuidados de higiene y manipulación de alimentos.
Ante la confirmación de un caso de Síndrome Urémico Hemolítico (SUH) en Hernando, las autoridades sanitarias locales informaron que ya se encuentran en marcha los protocolos de actuación y prevención correspondientes.
El niño afectado, de dos años, se encuentra internado en el Hospital de Niños de la ciudad de Córdoba, donde fue derivado el pasado sábado tras haber ingresado al Hospital Municipal Pascual A. Tirro con síntomas compatibles con la enfermedad, como diarrea y vómitos. El diagnóstico fue confirmado por el centro de salud cordobés.
La Secretaría de Salud, la Dirección de Bromatología y Ambiente y el Juzgado Administrativo de Faltas trabajan en el seguimiento del caso. Hasta el momento, la Municipalidad de Hernando no recibió notificación oficial de las autoridades provinciales respecto al origen del contagio, aunque los primeros indicios apuntan a que podría haberse producido en el ámbito doméstico, sin relación con comercios locales.
El SUH es una enfermedad grave que afecta principalmente a niños y niñas menores de cinco años, y puede provocar daño renal, destrucción de glóbulos rojos y alteraciones en las plaquetas. Generalmente es causada por la bacteria Escherichia coli, presente en alimentos contaminados o en la falta de higiene durante su manipulación.
Síntomas más frecuentes:
- Diarrea (a veces con sangre)
- Vómitos
- Fiebre
- Debilidad o irritabilidad
- Somnolencia
- Disminución en la producción de orina
Recomendaciones para prevenir el SUH:
- No ofrecer carne picada o alimentos derivados (hamburguesas, embutidos) a niños pequeños.
- Cocinar completamente las carnes, especialmente la picada.
- Lavarse las manos frecuentemente, especialmente antes de manipular alimentos.
- Evitar la contaminación cruzada entre carnes crudas y verduras.
- Lavar frutas y verduras con agua segura.
- Mantener los alimentos refrigerados y no dejarlos a temperatura ambiente.
- Comprar solo en comercios habilitados y con controles bromatológicos.
Si bien el menor ha mostrado signos de mejoría, la situación ha generado preocupación en la comunidad, donde familiares y allegados impulsan una cadena de oración a través de redes sociales.
Las autoridades recordaron que se trata, por ahora, de un caso aislado, pero insistieron en la importancia de la prevención y la consulta médica inmediata ante la aparición de síntomas.